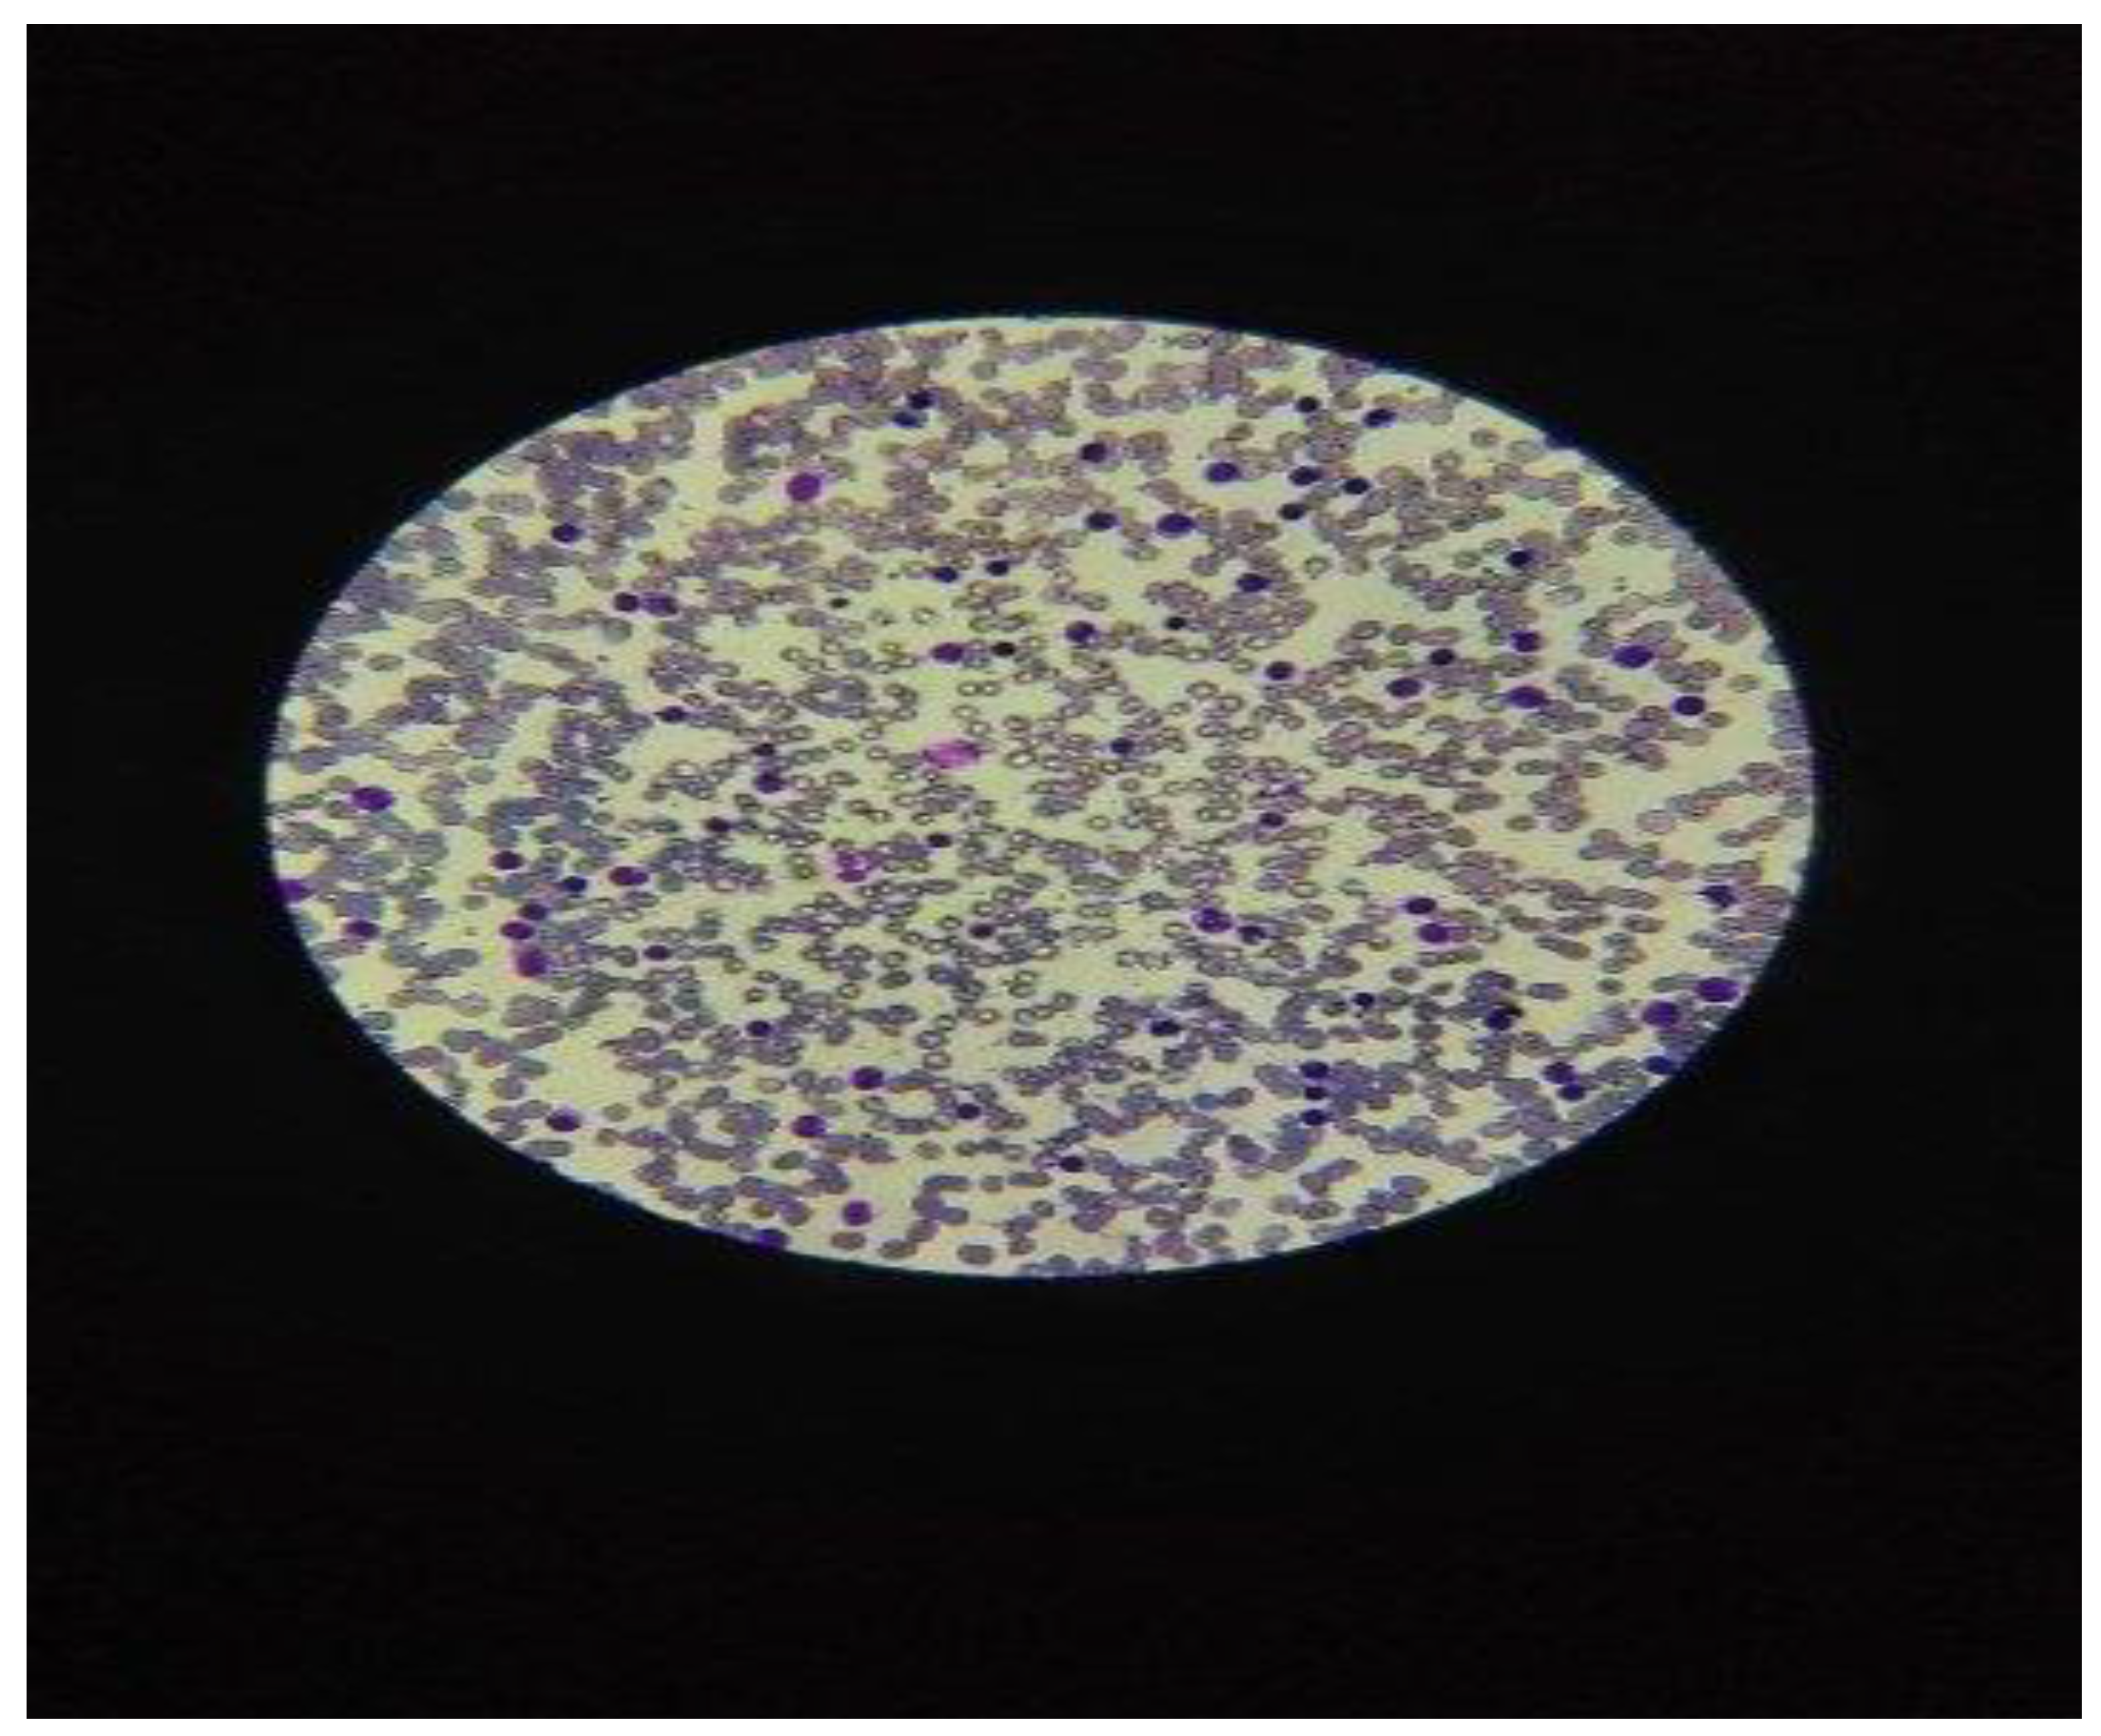
Preprints 112216 g002

1. Introduction
CLL, the most common leukemia in adults and the elderly, is characterized by clinical stages with unpredictable evolutions regardless of age or sex, men or women, affecting men to women in approximately 2:1 report. In the last decade, through various methods of paraclinical investigations, several features have been identified that can predict the evolution of the disease or the survival of patients with CLL. Among these between factors which control and regulate the apoptosis process and progression of the CLL disease IN patients, p53 protein and p21 protein are considered to be of major importance. [
1].
In CLL relapsed, p53 protein function is inactivated by P53 gene mutations that lead to the production of an isoform p53 protein with modified structure by amino acid substitution, in poly-morpho-variant forms, with increased stability in type B lymphocytes, [
3,
4]. This leads to the identification and quantification of the p53 protein by different immunohistochemical methods (IHC) polymerase chain reaction (PCR), single-stranded microarray peptide (SNP), next-generation sequencing (NGS) or sandwich immunoassay enzyme linked Immuno-absorbent Assay (ELISA). [
2]. P53 gene distinct isoforms of the p53 protein, which may disrupt its transcriptional activity, [
3,
4,
5], [
Figure 1].
2. Theory and Formula
This paper analyses the cases of chronic lymphocytic leukeemia type B, (CLL-B), which did not meet the standard treatment criteria for malignant hematologic diseases due to mutations in the P53 gene, with progression forward to Diffuse Large Lymphoma. Identifying different P53 gene mutations is very important because these mutations have an impact on the patient's clinical course in CLL with the p53 protein mutant isoform.
3. Experimental Setup
Hematologic samples were acquired from current clinician doctors of government hospitals that collected blood samples from patients with the diagnosis of B-CLL with a poor response to conventional chemotherapy and radiotherapy after two cycles of oncologic treatments. All patients signed the individual accord to be supplementary investigated the blood samples with CLL.
In the diagnosis of CLL and clinical staging were used the criteria recommended by the International Workshop on CLL, [
6]. The patients underwent the evaluation in a complete physical exam for the diagnosis of chronic lymphocytic leukemia-type B, (CLL-B), which presented symptoms such as frequent cough, night sweats and retrosternal pain. The diagnosis of CLL was prior established by the cytologic exam of a blood smear from peripheral blood, in microscopy exam, with> 5000 lymphocytes in absolute value and less than 10% prolymphocytes in the hemogram with 5 Differential count, (CBC), [
Figure 2].
The laboratory diagnosis of B-CLL was confirmed with the immunophenotyping using Flow Cytometry method, using the monoclonal antibodies in CD5⁺, CD19⁺, CD20⁺⁻, and CD23⁺ receptors, [
7,
8].
4. Result Discussions
Results obtained by the ELISA method: This analysis is based on the sandwich ELISA principle. Each well of the microtiter plate was pre-coated with a specific target capture antibody. Standards or samples are added to the wells and the target antigen, in this case, the p53 protein which binds to the capture antibody. Prepared a standard curve from the serial dilution data with a concentration on the x-axis (logarithmic scale) from the absorption on the Y-axis ,(linear), which was made in conformity with the references protocol. After analyzing the 85 samples of blood with CLL, in different stages of disease evolution, starting with stage zero (stay and observe) and up to stage IV, the 20 patients were selected, eligible for this study, to be investigated for the detection of p53 protein isoforms. Very high pathological values in the 3 cases of isoform p53 protein were calculated in 2 men, (PM) in the value of 60 µg / dL, respectively at 40 µg / dL and in the case of females, PW), calculated in the amount of 140 µg / dL, with the transformation into Diffuse Large Lymphoma, (DLL),
Graphic 1.
P53 protein values concentrations analyzed on the ELISA line.
Graphic 1.
P53 protein values concentrations analyzed on the ELISA line.
Mutant P53 gene in 17 cases, after excluding the 3 out-line cases present in the study, was calculated at the mean value of 14.8 µg / dL, with Standard Deviation, STDEV = 6.46, CV = 0.4% and the probability index (NORMDIST), "p" was calculated in the value of p = 0.079. According to
Table 1, the average hemogram results are as follows: leukocyte numberer = 35–50 x 103/dL, platelets = 140 x 103/dL, hemoglobin = 11.8 g/dL, and lymphocytes in peripheral blood = 65–80%, [
Table 1].
The table 1 shows that in the CLL stage III/IV (n = 3 patients), p53 isoform protein proportion
with elevated values was present in 15% (3 of 20 cases); 2 men had values of 50μg and 60μg/dL, respectively, and 1 female had a value of 140μg/dL (p-value 0.034); hematological parameters in peripheral blood altered, with leukocyte numbers of 250–500 x 10 3 /Dl. The average p53 protein concentration was found to be 16.76 μg/dL in the 17 instances with p-53 protein expression after the three out-of-line cases were excluded from the study.
Total number of cases with abnormal values (including p53 variants) above the cutoff x 100 = 3/3 = 100% (CI 95%). Using the calculation for the "t" statistic, it was found that "t" = 2. 2.01 and − 2.01 are the critical values derived from the "t" distribution over 20 degrees of freedom for a two-sided test at the conventional significance level of α = 0.05. Numerous studies have shown that P53 gene mutations are commonly detected in two chromosome 17p alleles and constitute over 15% of CLL patients, [
9,
10,
11].
In an international study, 103 LLC cases were investigated for the impact of p53 protein expression with its β and γ isoforms. In several global investigations, immunohistochemistry (IHC) was used to assess the immune traits of CLL patients who tested positive for the p-53 protein. 47 patients participated in the study's second component, which looked at CLL in stages I and II. In 16.7% of the samples (7 out of 42 instances) that were examined, the P-53 protein isoform concentration in reactive lymphocyte B was discovered, [
Table 2]
Between the two methods, ELISA, ICC, the CC, Pearson (r) Correlation Coefficient was calculated according to the following formula,
where: x, y is the sum of the products between the two variables = 567 and My are the averages of the two variables, 38,35 and 27,94, n = the number of subjects in the sample = 20 + 47 = 67, Sx and Sy are the standard deviations of the two variables, 8.25 and 17.35. It was observed that "r", CC obtained (0.74), is also significant at a level of significance higher than p <0.001, respectively 0.034. The (r) Pearson index can be significant, with "r" values being compared between 0.74 and 0.80, (> 0.50).
When the percentage of p53 positivity was correlated with the clinical stage of the disease, the proportion of positive p53 cases increased significantly from stage A Binet, (7.4%) stage B (24.4%) and stage C, (29.2%) (p = .002). The results of this study indicated that in CLL, p53 protein expression analyzed by an immunocytochemical method is strongly associated with p-53 gene mutations and a variant morphological analysis of p53.
Recent studies have shown that p53 protein deficiency promotes CLL Non-Hodgkin's Lymphoma and Diffuse Large Lymphoma (DLL), by eliminating its ability to limit aberrant self-renewal in hematopoietic progenitors, [
12]. Alteration of p53 protein function can induce cancer in cells. Replacing the amino acid serine in the p53 protein with the amino acid alanine resulted in preventing the p53 protein from inhibiting the cell cycle. Research has shown that restoring the function of the isomorphic p53 protein could lead to the regression of certain cancer cells without damaging other cells in the process, [
13]. Other studies have suggested that a high concentration of adenosine triphosphate (ATP) in malignant B-cell lymphocytes in CLL affected the P53 gene to induce cell apoptosis, [
14].
Antibodies specific for p53 and p53 for phosphorylated at three different sites in the field of activation used in parallel analyses in investigations of CLL treatments and are in current clinical trials, [
15]. The role of autophagy in cancer, which could be changed by p53 status, is expected to be developed in a new anti-cancer therapeutic, [
16,
17].
5. Conclusions
Mutant P53 gene, the most common genetic abnormalities of cancer have extensively studied in various mature B cell malignancies, including in CLL. In recent years, more attention has been paid to the importance of the mutant p53 expressed protein in CLL because of low survival of patients and non-response to classical conventional chemotherapy with progression to Diffuse Large Lymphoma.
Authors’ Disclosures of Potential Conflicts of Interest
No authors declared any potential conflicts of interest.
Grant/Funding support
not applicable.
Financial disclosures
not applicable.
Clinical trial registration
data availability statement, ethics approval statement, patient consent statement, permission to reproduce material from other sources: all are not applicable.
Acknowledgements
The author expresses the special thanks and his high appreciation to: Viviana Roman, Dr, CSP grade II, Center of Immunology, Institute Stefan S. Nicolau, Bucharest, Romania.
References
- Fischer, M., Census and evaluation of p53 target genes. Oncogene (2017) 36, 3943–3956.
- Sabapathy, K and Lane, DP (2019) Understanding p53 functions through p53 antibodies. J. Mol. Cell Biol 11, 1-35.
- Campo, E., Cymbalista, F., Ghia, P., Jäger, U., Pospisilova, S., Rosenquist, R., Schuh, A and Stilgenbauer, S.; (2018) TP53 aberrations in chronic lymphocytic leukaemia: an overview of the clinical implications of improved diagnostics. Haematologica103, 1956-1968. [CrossRef]
- Gonzalez, D., Martinez, P., Wade, R., Hockley, S.;,Oscier, D., Matutes, E., Dearden, CE., Richards, SM., Catovsky, D and Morgan, GJ., (2011) Mutational status of the TP53 gene as a predictor of response and survival in patients with chronic lymphocytic leukaemia: results from the LRF CLL4 trial. J Clin Oncol 29, 2223-2229. [CrossRef]
- Cordone, I., Masi, S., Mauro, FR., Soddu, S., Morsilli, O., Valentini, T., Vegna, ML., Guglielmi, C., Mancini, F., Giuliacci, S., Sacchi, A., Mandelli F and Foa, R.; (1998,) p53 expression in B-cell chronic lymphocytic leukaemia: a marker of disease progression and poor prognosis. Blood 91, 4342-4349.
- Hallek, M., Cheson, BD., Catovsky, D., Caligaris-Cappio, F., Dighiero, G., Döhner, H., Hillmen, P., Keating, M., Montserrat, E., Chiorazzi, N., Stilgenbauer, S., Rai, KR., Byrd, JC., Eichhorst, B., O'Brien, S., Robak, T., Seymour, JF and Kipps, TJ.; (2018). I will guidelines for diagnosis, indications for treatment, response assessment, and supportive management of CLL. Blood 21;131(25):2745-2760. [CrossRef]
- Cordone Masi, S., Mauro, FR., Soddu, S and Morsilli O.; (2019) p53 Expression in B-Cell Chronic Lymphocytic Leukemia: A Marker of Disease Progression and Poor Prognosis. Blood 91, 4342-4349.
- Bosch, F and Dalla- Favera., R (2022. Chronic lymphocytic leukaemia: from genetics to treatment. Nature review. Clinical Oncology; www.nature.
- Spiro, S., Galton, D.A.G., Wiltshaw, E and Lohmman., R.C.; (1975) Follicular Lymphoma: A survey of 75 cases with special references to the Syndrome resembling Chronic Lymphocytic Leukemia. Br. J. Cancer, Suppl. II, 60.
- Murnyák, B and Hortobágyi, T.; (2016) Immunohistochemical correlates of TP53 somatic mutations in cancer. Oncotarget 40, :64910-64920.
- Sellmann, L., Carpinteiro, A., Nückel, H., Scholtysik, R and Siemer, D., (2012) p53 protein expression in chronic lymphocytic leukemia. Leuk Lymphoma 53, 1282-1298.
- Allende-Vega, N., Krzywinska, E., Orecchioni,S., Lopez-Royuela, N., Reggiani, F., Talarico, G.; Rossi, JF., Rossignol, R., Hicheri, Y., Cartron, G., Bertolini, F and Villalba, M., (2015) The presence of wild type p53 in haematological cancers improves the efficacy of combinational therapy targeting metabolism. Oncotarget 22, 19228-19245. [CrossRef]
- Demma, M.J., Wong, S., Maxwell, E and Dasmahapatra M., (2004) 24–CP-31398 Restores DNA-binding Activity to Mutant p53 in Vitro but Does Not Affect p53 Homologs p63 and p73. The Journal of Biological Chemistry 279, 4, 45887–45896.
- Carpinteiro A., Nückel H., Scholtysik R and Siemer D., (2012) p53 protein expression in chronic lymphocytic leukemia, Blood Cancer Journal. 53(7):1282-1288.
- S.H. Van der Burg., Cock K and Menon A.G (2001) Long lasting p53-specific T cell memory responses in the absence of anti-p53 antibodies in patients with resected primary colorectal cancer, Eur. J. Immunol. 31, 146–155.
- Kondapuram, S.K., Sarvagalla, S and Coumar, M (2019) Targeting autophagy with small molecules for cancer therapy. Journal of Cancer Metastasis and Treatment 1, 23-25.
- Shahjahani, M.; Mohammadiasl, J.; Noroozi, F.; Seghatoleslami, M.; Shahrabi. S.; Saba, and Saki, N (2015) Molecular basis of chronic lymphocytic leukaemia diagnosis and prognosis. Cell Oncol 38, :93-109. [CrossRef]
|
Disclaimer/Publisher’s Note: The statements, opinions and data contained in all publications are solely those of the individual author(s) and contributor(s) and not of MDPI and/or the editor(s). MDPI and/or the editor(s) disclaim responsibility for any injury to people or property resulting from any ideas, methods, instructions or products referred to in the content. |
© 2024 by the authors. Licensee MDPI, Basel, Switzerland. This article is an open access article distributed under the terms and conditions of the Creative Commons Attribution (CC BY) license (http://creativecommons.org/licenses/by/4.0/).